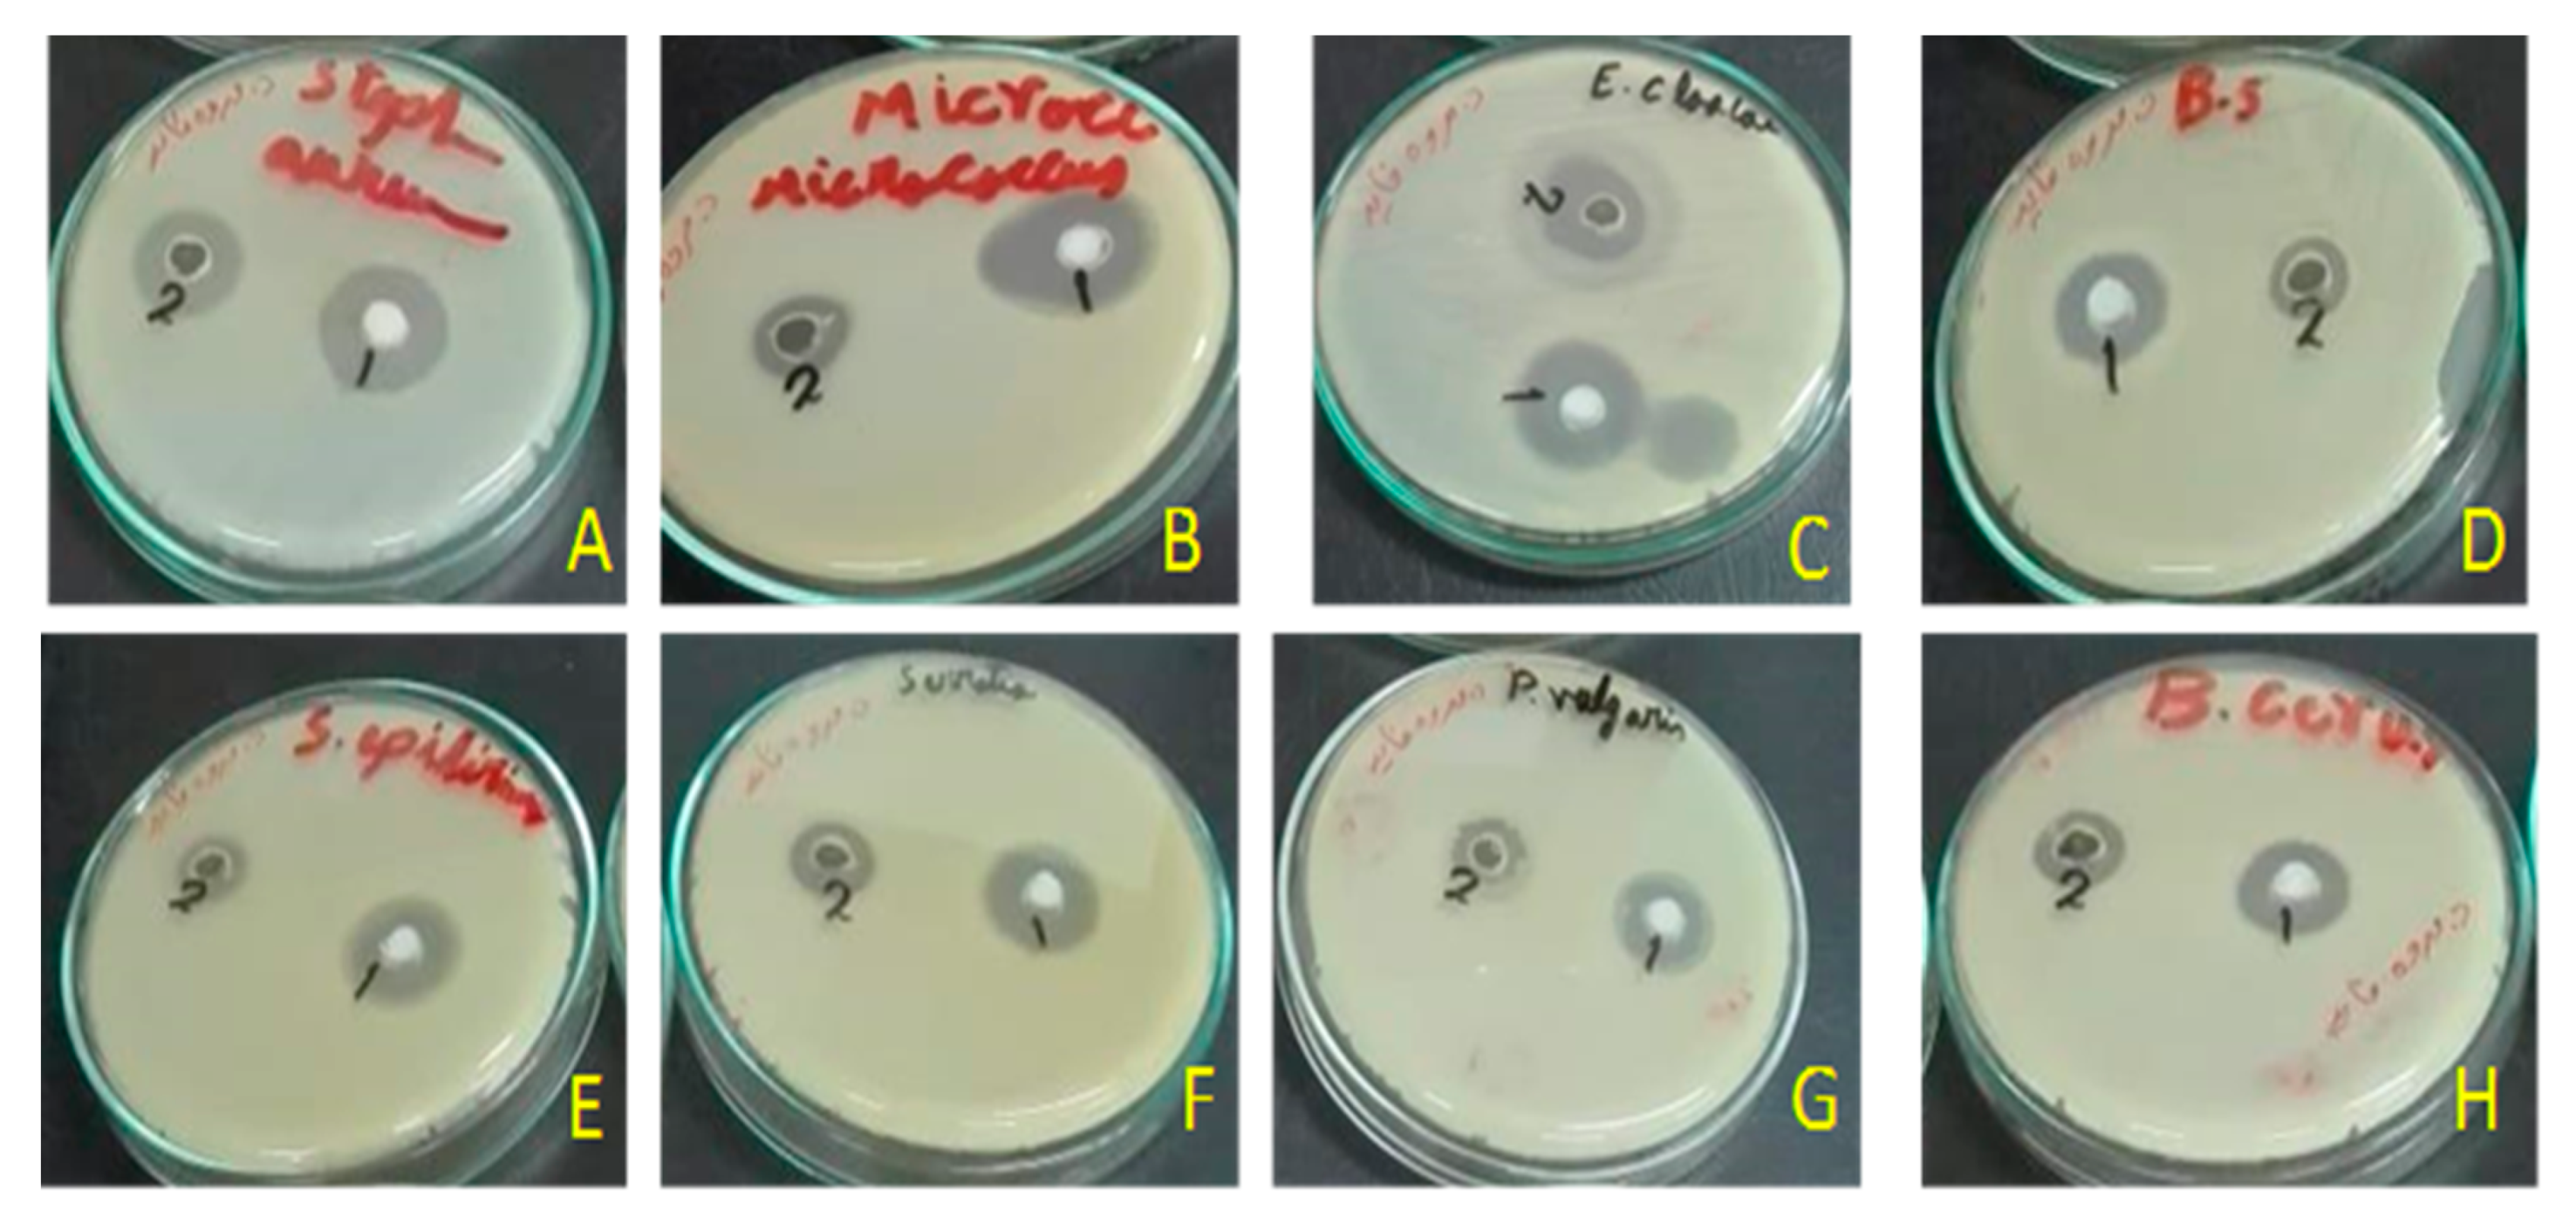
Metabolites 10 00353 g003 Metabolites 10 00353 g003

Characterization of Sunflower Oil Extracts from the Lichen Usnea barbata
Abstract
1. Introduction
2. Results
2.1. NMR-Based Determination of Usnic Acid in Oily Extracts of U. barbata
2.2. Estimation of Total Phenolic and Flavonoid Contents
2.3. Antimicrobial Activity
2.4. Cytotoxicity
3. Discussion
4. Conclusions
5. Materials and Methods
5.1. Materials and Extraction of U. barbata
5.2. Preparation of a Zinc Salt Precipitate
5.3. Quantification of UA by NMR
5.4. Quantification of Total Phenolics and Flavonoid
5.5. Antibiograms
5.6. Cytotoxicity
5.7. Statistical Analysis
Author Contributions
Funding
Acknowledgments
Conflicts of Interest
References
- Nikaido, H. Multidrug resistance in bacteria. Annu. Rev. Biochem. 2009, 78, 119–146. [Google Scholar] [CrossRef] [PubMed]
- Tarabees, R.; Gafar, K.M.; El-Sayed, M.S.; Shehata, A.A.; Ahmed, M. Effects of dietary supplementation of probiotic mix and prebiotic on growth performance, cecal microbiota composition, and protection against Escherichia coli O78 in broiler chickens. Probiotics Antimicrob Proteins 2019, 11, 981–989. [Google Scholar] [CrossRef] [PubMed]
- Tarabees, R.; El-Sayed, M.S.; Shehata, A.A.; Diab, M.S. Effects of the probiotic candidate E. faecalis-1, the poulvac E. coli vaccine, and their combination on growth performance, caecal microbial composition, immune response, and protection against E. coli O78 challenge in broiler chickens. Probiotics Antimicrob Proteins 2019. [Google Scholar] [CrossRef] [PubMed]
- Prestinaci, F.; Pezzotti, P.; Pantosti, A. Antimicrobial resistance: A global multifaceted phenomenon. Pathog. Glob. Health 2015, 109, 309–318. [Google Scholar] [CrossRef] [PubMed]
- Landoni, M.F.; Albarellos, G. The use of antimicrobial agents in broiler chickens. Vet. J. 2015, 205, 21–27. [Google Scholar] [CrossRef] [PubMed]
- Agunos, A.; Leger, D.; Carson, C. Review of antimicrobial therapy of selected bacterial diseases in broiler chickens in Canada. Can. Vet. J. 2012, 53, 1289–1300. [Google Scholar]
- Pagel, S.W.; Gautier, P. Use of antimicrobial agents in livestock. Rev. Sci. Tech. 2012, 31, 145–188. [Google Scholar] [CrossRef]
- Goetting, V.; Lee, K.A.; Tell, L.A. Pharmacokinetics of veterinary drugs in laying hens and residues in eggs: A review of the literature. J. Vet. Pharmacol. Ther. 2011, 34, 521–556. [Google Scholar] [CrossRef]
- Reig, M.; Toldra, F. Veterinary drug residues in meat: Concerns and rapid methods for detection. Meat. Sci. 2008, 78, 60–67. [Google Scholar] [CrossRef]
- Pendleton, J.N.; Gorman, S.P.; Gilmore, B.F. Clinical relevance of the ESKAPE pathogens. Expert. Rev. Anti. Infect. Ther. 2013, 11, 297–308. [Google Scholar] [CrossRef]
- Montoro-Dasi, L.; Villagra, A.; Sevilla-Navarro, S.; Perez-Gracia, M.T.; Vega, S.; Marin, C. The dynamic of antibiotic resistance in commensal Escherichia coli throughout the growing period in broiler chickens: Fast-growing vs. slow-growing breeds. Poult. Sci. 2020, 99, 1591–1597. [Google Scholar] [CrossRef] [PubMed]
- Drame, O.; Leclair, D.; Parmley, E.J.; Deckert, A.; Ouattara, B.; Daignault, D.; Ravel, A. Antimicrobial resistance of Campylobacter in broiler chicken along the food chain in Canada. Foodborne Pathog. Dis. 2020. [Google Scholar] [CrossRef] [PubMed]
- Abraham, S.; Sahibzada, S.; Hewson, K.; Laird, T.; Abraham, R.; Pavic, A.; Truswell, A.; Lee, T.; O’Dea, M.; Jordan, D. Emergence of fluoroquinolone-resistant Campylobacter jejuni and Campylobacter coli among Australian chickens in the absence of fluoroquinolone use. Appl. Environ. Microbiol. 2020, 86. [Google Scholar] [CrossRef] [PubMed]
- Fani, F.; Aminshahidi, M.; Firoozian, N.; Rafaatpour, N. Prevalence, antimicrobial resistance, and virulence-associated genes of Campylobacter isolates from raw chicken meat in Shiraz, Iran. Iran J. Vet. Res. 2019, 20, 283–288. [Google Scholar]
- Shehata, A.A.; Shereen, B.; Elrazek, A.A.; Sultan, H.; Elsayed, M.S.A.E.; Tarabees, R.; Talat, S.; Moharam, I.; Said, A.; Mohsen, W.A.; et al. Characterization of Salmonella enterica isolated from poultry hatcheries and commercial broiler chickens. Pak. Vet. J. 2019, 39, 515–520. [Google Scholar] [CrossRef]
- Asfaw Ali, D.; Tadesse, B.; Ebabu, A. Prevalence and antibiotic resistance pattern of Salmonella isolated from caecal contents of exotic chicken in Debre Zeit and Modjo, Ethiopia. Int. J. Microbiol. 2020, 2020, 1910630. [Google Scholar] [CrossRef]
- Bernier-Lachance, J.; Arsenault, J.; Usongo, V.; Parent, E.; Labrie, J.; Jacques, M.; Malouin, F.; Archambault, M. Prevalence and characteristics of livestock-associated methicillin-resistant Staphylococcus aureus (LA-MRSA) isolated from chicken meat in the province of Quebec, Canada. PLoS ONE 2020, 15, e0227183. [Google Scholar] [CrossRef]
- Kwoji, I.D.; Jauro, S.; Musa, J.A.; Lekko, Y.M.; Salihu, S.I.; Danchuwa, H.A. Phenotypic detection of methicillin-resistant Staphylococcus aureus in village chickens from poultry markets in Maiduguri, Nigeria. J. Adv. Vet. Anim. Res. 2019, 6, 163–167. [Google Scholar] [CrossRef]
- Kuhn, S.; Colreavy-Donnelly, S.; Santana de Souza, J.; Borges, R.M. An integrated approach for mixture analysis using MS and NMR techniques. Faraday Discuss. 2019, 218, 339–353. [Google Scholar] [CrossRef]
- Uma, K.; Huang, X.; Kumar, B.A. Antifungal effect of plant extract and essential oil. Chin. J. Integr. Med. 2017, 23, 233–239. [Google Scholar] [CrossRef]
- Aschenbrenner, I.A.; Cernava, T.; Berg, G.; Grube, M. Understanding microbial multi-species symbioses. Front. Microbiol. 2016, 7, 180. [Google Scholar] [CrossRef] [PubMed]
- Huneck, S. New results on the chemistry of lichen substances. In Fortschritte der Chemie Organischer Naturstoffe/Progress in the Chemistry of Organic Natural Products; Springer: Vienna, Austria, 2001; pp. 1–276. [Google Scholar]
- Molnar, K.; Farkas, E. Current results on biological activities of lichen secondary metabolites: A review. Z Nat. C J. Biosci. 2010, 65, 157–173. [Google Scholar] [CrossRef] [PubMed]
- Felczykowska, A.; Pastuszak-Skrzypczak, A.; Pawlik, A.; Bogucka, K.; Herman-Antosiewicz, A.; Guzow-Krzeminska, B. Antibacterial and anticancer activities of acetone extracts from in vitro cultured lichen-forming fungi. BMC Complement. Altern. Med. 2017, 17, 300. [Google Scholar] [CrossRef] [PubMed]
- Studzinska-Sroka, E.; Holderna-Kedzia, E.; Galanty, A.; Bylka, W.; Kacprzak, K.; Cwiklinska, K. In vitro antimicrobial activity of extracts and compounds isolated from Cladonia uncialis. Nat. Prod. Res. 2015, 29, 2302–2307. [Google Scholar] [CrossRef]
- Galanty, A.; Paśko, P.; Podolak, I. Enantioselective activity of usnic acid: A comprehensive review and future perspectives. Phytochem. Rev. 2019, 18, 527–548. [Google Scholar] [CrossRef]
- Boustie, J.; Tomasi, S.; Grube, M. Bioactive lichen metabolites: Alpine habitats as an untapped source. Phytochem. Rev. 2011, 10, 287–307. [Google Scholar] [CrossRef]
- Xu, M.; Heidmarsson, S.; Olafsdottir, E.S.; Buonfiglio, R.; Kogej, T.; Omarsdottir, S. Secondary metabolites from cetrarioid lichens: Chemotaxonomy, biological activities and pharmaceutical potential. Phytomedicine 2016, 23, 441–459. [Google Scholar] [CrossRef] [PubMed]
- Esimone, C.O.; Ofokansi, K.C.; Adikwu, M.U.; Ibezim, E.C.; Abonyi, D.O.; Odaibo, G.N.; Olaleye, D.O. In vitro evaluation of the antiviral activity of extracts from the lichen Parmelia perlata (L.) Ach. against three RNA viruses. J. Infect. Dev. Ctries. 2007, 1, 315–320. [Google Scholar] [CrossRef] [PubMed]
- Rankovic, B.; Misic, M.; Sukdolak, S. Evaluation of antimicrobial activity of the lichens Lasallia pustulata, Parmelia sulcata, Umbilicaria crustulosa, and Umbilicaria cylindrica. Mikrobiologiia 2007, 76, 817–821. [Google Scholar] [CrossRef]
- Rankovic, B.; Misic, M.; Sukdolak, S. Antimicrobial activity of extracts of the lichens Cladonia furcata, Parmelia caperata, Parmelia pertusa, Hypogymnia physodes and Umbilicaria polyphylla. Br. J. Biomed. Sci. 2007, 64, 143–148. [Google Scholar] [CrossRef]
- Prateeksha, P.; Paliya, B.S.; Bajpai, R.; Jadaun, V.; Kumar, J.; Kumar, S.; Upreti, D.K.; Singh, B.R.; Nayaka, S.; Joshi, Y.; et al. The genus Usnea: A potent phytomedicine with multifarious ethnobotany, phytochemistry and pharmacology. RSC Adv. 2016, 6, 21672–21696. [Google Scholar] [CrossRef]
- Ingolfsdottir, K. Usnic acid. Phytochemistry 2002, 61, 729–736. [Google Scholar] [CrossRef]
- Cocchietto, M.; Skert, N.; Nimis, P.L.; Sava, G. A review on usnic acid, an interesting natural compound. Naturwissenschaften 2002, 89, 137–146. [Google Scholar] [CrossRef] [PubMed]
- Shukla, P.; Upreti, D.; Tewari, L. Secondary metabolite variability in lichen genus Usnea in India: A potential source for bioprospection. J. Environ. Sci. Technol. 2015, 2, 44–55. [Google Scholar]
- Kinoshita, Y.; Yamamoto, Y.; Yoshimura, I.; Kurokawa, T.; Huneck, S. Distribution of optical isomers of usnic and isousnic acids analyzed by high performance liquid chromatography. Hattori Bot. Lab. 1997, 83, 173–178. [Google Scholar]
- Lucarini, R.; Tozatti, M.; De, A.; Salloum, O.; Crotti, A.E.; Silva, M.; Gimenez, V.; Groppo, M.; Januario, A.H.; Martins, C.H.; et al. Antimycobacterial activity of Usnea steineri and its major constituent (+)-usnic acid. Afr. J. Biotechnol. 2012, 11, 4636–4639. [Google Scholar] [CrossRef]
- Zugic, A.; Jeremic, I.; Isakovic, A.; Arsic, I.; Savic, S.; Tadic, V. Evaluation of anticancer and antioxidant activity of a commercially available CO2 supercritical extract of Old Man’s Beard (Usnea barbata). PLoS ONE 2016, 11, e0146342. [Google Scholar] [CrossRef]
- Ivanovic, J.; Meyer, F.; Misic, D.; Asanin, J.; Jaeger, P.; Zizovic, I.; Eggers, R. Influence of different pre-treatment methods on isolation of extracts with strong antibacterial activity from lichen Usnea barbata using carbon dioxide as a solvent. J. Supercrit. Fluids 2013, 76, 1–9. [Google Scholar] [CrossRef]
- Hsu, L.M.; Huang, Y.S.; Chang, F.Y.; Lee, S.D. ‘Fat burner’ herb, usnic acid, induced acute hepatitis in a family. J. Gastroenterol. Hepatol. 2005, 20, 1138–1139. [Google Scholar] [CrossRef]
- Sonko, B.J.; Schmitt, T.C.; Guo, L.; Shi, Q.; Boros, L.G.; Leakey, J.E.; Beger, R.D. Assessment of usnic acid toxicity in rat primary hepatocytes using 13C isotopomer distribution analysis of lactate, glutamate and glucose. Food Chem. Toxicol. 2011, 49, 2968–2974. [Google Scholar] [CrossRef]
- Yellapu, R.K.; Mittal, V.; Grewal, P.; Fiel, M.; Schiano, T. Acute liver failure caused by ’fat burners’ and dietary supplements: A case report and literature review. Can. J. Gastroenterol. 2011, 25, 157–160. [Google Scholar] [CrossRef] [PubMed]
- Lauterwein, M.; Oethinger, M.; Belsner, K.; Peters, T.; Marre, R. In vitro activities of the lichen secondary metabolites vulpinic acid, (+)-usnic acid, and (-)-usnic acid against aerobic and anaerobic microorganisms. Antimicrob. Agents Chemother. 1995, 39, 2541–2543. [Google Scholar] [CrossRef] [PubMed]
- Wu, J.; Zhang, M.; Ding, D.; Tan, T.; Yan, B. Effect of Cladonia alpestris on Trichomonas vaginalis in vitro. Zhongguo Ji Sheng Chong Xue Yu Ji Sheng Chong Bing Za Zhi 1995, 13, 126–129. [Google Scholar] [PubMed]
- Shang, X.; Miao, X.; Lv, H.; Wang, D.; Zhang, J.; He, H.; Yang, Z.; Pan, H. Acaricidal activity of usnic acid and sodium usnic acid against Psoroptes cuniculi in vitro. Parasitol. Res. 2014, 113, 2387–2390. [Google Scholar] [CrossRef]
- Martins, M.C.; Silva, M.C.; Silva, L.R.; Lima, V.L.; Pereira, E.C.; Falcao, E.P.; Melo, A.M.; da Silva, N.H. Usnic acid potassium salt: An alternative for the control of Biomphalaria glabrata (Say, 1818). PLoS ONE 2014, 9, e111102. [Google Scholar] [CrossRef]
- Scirpa, P.; Scambia, G.; Masciullo, V.; Battaglia, F.; Foti, E.; Lopez, R.; Villa, P.; Malecore, M.; Mancuso, S. A zinc sulfate and usnic acid preparation used as post-surgical adjuvant therapy in genital lesions by Human Papillomavirus. Minerva Ginecol. 1999, 51, 255–260. [Google Scholar]
- Kuhn, V.; Geisberger, T.; Huber, C.; Beck, A.; Eisenreich, W. A facile in vivo procedure to analyze metabolic pathways in intact lichens. New Phytol. 2019, 224, 1657–1667. [Google Scholar] [CrossRef]
- Shehata, A.A.; Schrödl, W.; Aldin, A.A.; Hafez, H.M.; Krüger, M. The effect of glyphosate on potential pathogens and beneficial members of poultry microbiota in vitro. Curr. Microbiol. 2013, 66, 350–358. [Google Scholar] [CrossRef]
- Shehata, A.A.; Sultan, H.; Hafez, H.M.; Krüger, M. Safety and efficacy of a metabolic drift live attenuated Salmonella gallinarum vaccine against fowl typhoid. Avian Dis. 2013, 57, 29–35. [Google Scholar] [CrossRef]
- Krüger, M.; Shehata, A.A.; Schrödl, W.; Rodloff, A. Glyphosate suppresses the antagonistic effect of Enterococcus spp. on Clostridium botulinum. Anaerobe 2013, 20, 74–78. [Google Scholar] [CrossRef]
- Cansaran, D.; Kahya, D.; Yurdakulola, E.; Atakol, O. Identification and quantitation of usnic acid from the lichen Usnea species of Anatolia and antimicrobial activity. Z. Naturforsch. C J. Biosci. 2006, 61, 773–776. [Google Scholar] [CrossRef]
- Idamokoro, E.M.; Masika, P.J.; Muchenje, V.; Falta, D.; Green, E. In-vitro antibacterial sensitivity of Usnea barbata lichen extracted with methanol and ethyl-acetate against selected Staphylococcus species from milk of cows with mastitis. Archiv. Fur. Tierzucht. 2014, 57, 1–9. [Google Scholar] [CrossRef]
- Popovici, V.; Bucur, L.; Popescu, A.; Caraiane, A.; Badea, V. Determination of the content in usnic acid and polyphenols from the extracts of Usnea barbata L. and the evaluation of their antioxidant activity. Farmacia 2018, 66, 337–341. [Google Scholar]
- Rankovic, B.; Kosanic, M.; Stanojkovic, T.; Vasiljevic, P.; Manojlovic, N. Biological activities of Toninia candida and Usnea barbata together with their norstictic acid and usnic acid constituents. Int. J. Mol. Sci. 2012, 13, 14707–14722. [Google Scholar] [CrossRef] [PubMed]
- Popovici, V.; Bucur, L.; Costache, T.; Gherghel, D.; Vochița, G.; Mihai, C.T.; Rotinberg, P.; Schroder, V.; florin ciprian, B.; Badea, V. Studies on preparation and UHPLC analysis of the Usnea barbata (L) F.H.Wigg dry acetone extract. Rev. Roum. Chim. 2019, 70, 3775–3777. [Google Scholar] [CrossRef]
- Cansaran-Duman, D.; Aras, S.; Atakol, O. Determination of usnic acid content in some lichen species found in Anatolia. JABS 2008, 23, 41–44. [Google Scholar]
- Cansaran, D.; Cetin, D.; Halici, M.G.; Atakol, O. Determination of usnic acid in some Rhizoplaca species from Middle Anatolia and their antimicrobial activities. Z. Naturforsch. C J. Biosci. 2006, 61, 47–51. [Google Scholar] [CrossRef]
- Shibata, S.; Ukita, T.; Tamura, T.; Miura, Y. Relation between chemical constitutions and antibacterial effects of usnic acid and its derivatives. Jpn. J. Med. 1948, 1, 152–155. [Google Scholar] [CrossRef]
- Francolini, I.; Norris, P.; Piozzi, A.; Donelli, G.; Stoodley, P. Usnic acid, a natural antimicrobial agent able to inhibit bacterial biofilm formation on polymer surfaces. Antimicrob Agents Chemother 2004, 48, 4360–4365. [Google Scholar] [CrossRef]
- Olsen, R.H.; Frantzen, C.; Christensen, H.; Bisgaard, M. An investigation on first-week mortality in layers. Avian. Dis. 2012, 56, 51–57. [Google Scholar] [CrossRef]
- Blanco, A.E.; Barz, M.; Icken, W.; Cavero, D.; Mazaheri, A.; Voss, M.; Schmutz, M.; Preisinger, R. Twenty years of amyloid arthropathy research in chickens. World Poult. Sci. J. 2016, 72, 495–508. [Google Scholar] [CrossRef]
- Tankson, J.D.; Thaxton, J.P.; Vizzier-Thaxton, Y. Pulmonary hypertension syndrome in broilers caused by Enterococcus faecalis. Infect. Immun. 2001, 69, 6318–6322. [Google Scholar] [CrossRef] [PubMed]
- Gregersen, R.H.; Petersen, A.; Christensen, H.; Bisgaard, M. Multilocus sequence typing of Enterococcus faecalis isolates demonstrating different lesion types in broiler breeders. Avian Pathol. 2010, 39, 435–440. [Google Scholar] [CrossRef]
- Moore, W.E.C.; Gross, W.B. Liver granulomas of turkeys: Causative agents and mechanism of infection. Avian Dis. 1968, 12, 417–422. [Google Scholar] [CrossRef] [PubMed]
- Maasjost, J.; Mühldorfer, K.; Cortez de Jäckel, S.; Hafez, H.M. Antimicrobial susceptibility patterns of Enterococcus faecalis and Enterococcus faecium isolated from poultry flocks in Germany. Avian Dis. 2015, 59, 143–148. [Google Scholar] [CrossRef]
- Maasjost, J.; Lüschow, D.; Kleine, A.; Hafez, H.M.; Mühldorfer, K. Presence of virulence genes in Enterococcus species isolated from meat turkeys in Germany does not correlate with chicken embryo lethality. Biomed. Res. Int. 2019, 2019, 6147695. [Google Scholar] [CrossRef] [PubMed]
- NNIS. National nosocomial infections surveillance (NNIS) system report, data summary from January 1992-June 2001, issued August 2001. Am. J. Infect. Control. 2001, 29, 404–421. [Google Scholar] [CrossRef]
- Singh, K.V.; Nallapareddy, S.R.; Sillanpaa, J.; Murray, B.E. Importance of the collagen adhesin ace in pathogenesis and protection against Enterococcus faecalis experimental endocarditis. PLoS Pathog. 2010, 6, e1000716. [Google Scholar] [CrossRef]
- Singh, K.V.; Nallapareddy, S.R.; Murray, B.E. Importance of the ebp (endocarditis- and biofilm-associated pilus) locus in the pathogenesis of Enterococcus faecalis ascending urinary tract infection. J. Infect. Dis. 2007, 195, 1671–1677. [Google Scholar] [CrossRef]
- Thurlow, L.R.; Thomas, V.C.; Narayanan, S.; Olson, S.; Fleming, S.D.; Hancock, L.E. Gelatinase contributes to the pathogenesis of endocarditis caused by Enterococcus faecalis. Infect. Immun. 2010, 78, 4936–4943. [Google Scholar] [CrossRef]
- Elo, H.; Matikainen, J.; Pelttari, E. Potent activity of the lichen antibiotic (+)-usnic acid against clinical isolates of vancomycin-resistant enterococci and methicillin-resistant Staphylococcus aureus. Naturwissenschaften 2007, 94, 465–468. [Google Scholar] [CrossRef] [PubMed]
- Koparal, A.T.; Tuylu, B.A.; Turk, H. In vitro cytotoxic activities of (+)-usnic acid and (-)-usnic acid on V79, A549, and human lymphocyte cells and their non-genotoxicity on human lymphocytes. Nat. Prod. Res. 2006, 20, 1300–1307. [Google Scholar] [CrossRef] [PubMed]
- Bazin, M.A.; Le Lamer, A.C.; Delcros, J.G.; Rouaud, I.; Uriac, P.; Boustie, J.; Corbel, J.C.; Tomasi, S. Synthesis and cytotoxic activities of usnic acid derivatives. Bioorg. Med. Chem. 2008, 16, 6860–6866. [Google Scholar] [CrossRef]
- Yu, X.; Guo, Q.; Su, G.; Yang, A.; Hu, Z.; Qu, C.; Wan, Z.; Li, R.; Tu, P.; Chai, X. Usnic acid derivatives with cytotoxic and antifungal activities from the lichen Usnea longissima. J. Nat. Prod. 2016, 79, 1373–1380. [Google Scholar] [CrossRef] [PubMed]
- Zheng, J.; Zhang, Y.; Xu, W.; Luo, Y.; Hao, J.; Shen, X.L.; Yang, X.; Li, X.; Huang, K. Zinc protects HepG2 cells against the oxidative damage and DNA damage induced by ochratoxin A. Toxicol. Appl. Pharmacol. 2013, 268, 123–131. [Google Scholar] [CrossRef] [PubMed]
- Mo, J.; Lin, D.; Wang, J.; Li, P.; Liu, W. Apoptosis in HepG2 cells induced by zinc pyrithione via mitochondrial dysfunction pathway: Involvement of zinc accumulation and oxidative stress. Ecotoxicol. Environ. Saf. 2018, 161, 515–525. [Google Scholar] [CrossRef] [PubMed]
- Liedek, E.; Haegele, G. Zinc and/or Lead Salts of Carboxylic Acids and Their Use as Corrosion Inhibitors. U.S. Patent No. 4,830,775, 16 May 1989. [Google Scholar]
- Chun, O.K.; Kim, D.O.; Lee, C.Y. Superoxide radical scavenging activity of the major polyphenols in fresh plums. J. Agric. Food Chem. 2003, 51, 8067–8072. [Google Scholar] [CrossRef]
- Herald, T.J.; Gadgil, P.; Tilley, M. High-throughput micro plate assays for screening flavonoid content and DPPH-scavenging activity in sorghum bran and flour. J. Sci. Food Agric. 2012, 92, 2326–2331. [Google Scholar] [CrossRef]
- Hindler, J.A.; Howard, B.J.; Keiser, J.F. Antimicrobial Agents and Susceptibility Testing. In Clinical and Pathogenic Microbiology; Howard, B.J., Ed.; Mosby-Year Book Inc.: St. Louis, MO, USA, 1994. [Google Scholar]
- Bismarck, D.; Schneider, M.; Müller, E. Antibakterielle In-vitro-Wirksamkeit ätherischer Öle gegen veterinärmedizinisch relevante Keime klinischer Isolate von Hunden, Katzen und Pferden. Complement Med. Res. 2017, 24, 153–163. [Google Scholar] [CrossRef]

| Bacterial Isolates | Reference/Lab. No. | Media Used for Antibiogram | History of Isolates | References |
|---|---|---|---|---|
| Staphylococcus aureus | 11/12 | Mueller–Hinton agar | Commercial broilers showing arthritis | [49] |
| Staphylococcusaureus 2 | Staph-2/20 | Mueller–Hinton agar | Isolated from one-week old commercial broilers chicks allocated in 10 different farms suffering from arthritis and omphalitis. Isolation was done on blood agar (Fluka, Steinheim, Germany) and identified using biochemical tests (data not shown) | this study |
| Staphylococcus aureus -3 | Staph-3/20 | Mueller–Hinton agar | this study | |
| Staphylococcus aureus -4 | Staph-4/20 | Mueller–Hinton agar | this study | |
| Staphylococcus aureus -5 | Staph-5/20 | Mueller–Hinton agar | this study | |
| Staphylococcus aureus -6 | Staph-6/20 | Mueller–Hinton agar | this study | |
| Staphylococcus aureus -7 | Staph-7/20 | Mueller–Hinton agar | this study | |
| Staphylococcus aureus -8 | Staph-8/20 | Mueller–Hinton agar | this study | |
| Staphylococcus aureus -9 | Staph-9/20 | Mueller–Hinton agar | this study | |
| Staphylococcus aureus -10 | Staph-10/20 | Mueller–Hinton agar | this study | |
| Salmonella Gallinarum | Z34/11 | Caso-agar | Commercial broiler chickens showing diarrhea, pasty vent, and high mortality rates | [50] |
| Salmonella Enteritidis-1 | SE-1 | Caso-agar | Commercial broiler chicken | [51] |
| Salmonella Enteritidis-2 | SE-2 | Caso-agar | Commercial broiler chicken showing diarrhea and mortalities | [15] |
| Salmonella Typhimurium-1 | ST-1 | Caso-agar | [15] | |
| Salmonella Typhimurium-2 | ST-2 | Caso-agar | [15] | |
| E. coli-1 | E-1/20 | Mueller–Hinton agar | Isolated from visceral organs (livers, lungs, hearts, and spleens) collected from diseased and freshly dead broiler chickens in 10 farms. Chickens aged from 15 to 35 days old. The main gross lesions were perihepatitis, pericarditis, and airsacculitis. Isolation was carried out on MacConkey agar (Merck, Darmstadt, Germany) and identified based on colonial morphological characters, and Analytical Profile Index (API 20E, Bio-Merck, Martillac, France) (data not shown) | this study |
| E. coli-2 | E-2/20 | Mueller–Hinton agar | this study | |
| E. coli-3 | E-3/20 | Mueller–Hinton agar | this study | |
| E. coli-4 | E-4/20 | Mueller–Hinton agar | this study | |
| E. coli-5 | E-5/20 | Mueller–Hinton agar | this study | |
| E. coli-6 | E-6/20 | Mueller–Hinton agar | this study | |
| E. coli-7 | E-7/20 | Mueller–Hinton agar | this study | |
| E. coli-8 | E-8/20 | Mueller–Hinton agar | this study | |
| E. coli-9 | E-9/20 | Mueller–Hinton agar | this study | |
| E. coli-10 | E-10/20 | Mueller–Hinton agar | this study | |
| E. faecalis-1 | EF-1/20 | Mueller–Hinton agar | Isolated from gastrointestinal tract of commercial broiler chickens suffering from E. coli infection (see above). Isolation was done on Citrate-Azid-Tween-Carbonate agar (Oxoid, Wesel, Germany) and identified based on biochemical tests (data not shown) | this study |
| E. faecalis-2 | EF-2/20 | Mueller–Hinton agar | this study | |
| E. faecalis-3 | EF-3/20 | Mueller–Hinton agar | this study | |
| E. faecalis-4 | EF-4/20 | Mueller–Hinton agar | this study | |
| E. faecalis-5 | EF-5/20 | Mueller–Hinton agar | this study | |
| E. faecalis-6 | EF-6/20 | Mueller–Hinton agar | this study | |
| E. faecalis-7 | EF-7/20 | Mueller–Hinton agar | this study | |
| E. faecalis-8 | EF-8/20 | Mueller–Hinton agar | this study | |
| E. faecalis-9 | EF-9/20 | Mueller–Hinton agar | this study | |
| E. faecalis-10 | EF-10/20 | Mueller–Hinton agar | this study |
| Tested Sample | % Viability (Means ± SEM, n = 6) | |||
|---|---|---|---|---|
| MCF-7 | HEPG-2 | |||
| 10 µL/mL | 100 µL/mL | 10 µL/mL | 100 µL/mL | |
| Total extract | 97.9 ± 2.46 | 31.3 ± 2.87 *** | 93.4 ± 2.92 | 46.4 ± 1.17 *** |
| Prepared zinc salt | 90.0 ± 2.94 | 43.5 ± 5.84 *** | 98.2 ± 1.27 | 5.7 ± 1.89 ***# |
© 2020 by the authors. Licensee MDPI, Basel, Switzerland. This article is an open access article distributed under the terms and conditions of the Creative Commons Attribution (CC BY) license (http://creativecommons.org/licenses/by/4.0/).
Share and Cite
Basiouni, S.; Fayed, M.A.A.; Tarabees, R.; El-Sayed, M.; Elkhatam, A.; Töllner, K.-R.; Hessel, M.; Geisberger, T.; Huber, C.; Eisenreich, W.; et al. Characterization of Sunflower Oil Extracts from the Lichen Usnea barbata. Metabolites 2020, 10, 353. https://doi.org/10.3390/metabo10090353
Basiouni S, Fayed MAA, Tarabees R, El-Sayed M, Elkhatam A, Töllner K-R, Hessel M, Geisberger T, Huber C, Eisenreich W, et al. Characterization of Sunflower Oil Extracts from the Lichen Usnea barbata. Metabolites. 2020; 10(9):353. https://doi.org/10.3390/metabo10090353
Chicago/Turabian StyleBasiouni, Shereen, Marwa A. A. Fayed, Reda Tarabees, Mohamed El-Sayed, Ahmed Elkhatam, Klaus-Rainer Töllner, Manfred Hessel, Thomas Geisberger, Claudia Huber, Wolfgang Eisenreich, and et al. 2020. "Characterization of Sunflower Oil Extracts from the Lichen Usnea barbata" Metabolites 10, no. 9: 353. https://doi.org/10.3390/metabo10090353
APA StyleBasiouni, S., Fayed, M. A. A., Tarabees, R., El-Sayed, M., Elkhatam, A., Töllner, K.-R., Hessel, M., Geisberger, T., Huber, C., Eisenreich, W., & Shehata, A. A. (2020). Characterization of Sunflower Oil Extracts from the Lichen Usnea barbata. Metabolites, 10(9), 353. https://doi.org/10.3390/metabo10090353

